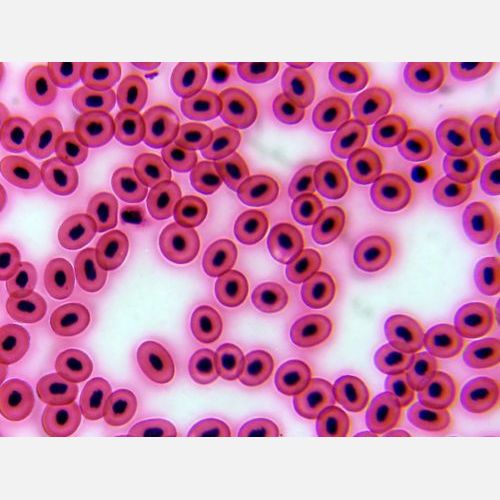

動物組織プレパラートC A4 94735 アーテック
通常価格:¥ 3,945 税込
¥ 3,945 税込
商品コード: y060283-000-000
JANコード:
4521718947358
関連カテゴリ
【商品説明】
動物組織の構造が観察できる、プレパラートセットです。10種各1枚 横紋筋、平滑筋、心筋、肝臓、肺臓、膵臓、軟骨、回虫の横断、カエルの血球、人の血球76×26×1.5mm60gガラス白箱入100×85×27mm
- この商品のレビュー ☆☆☆☆☆ (0)
- この商品のレビュー ☆☆☆☆☆